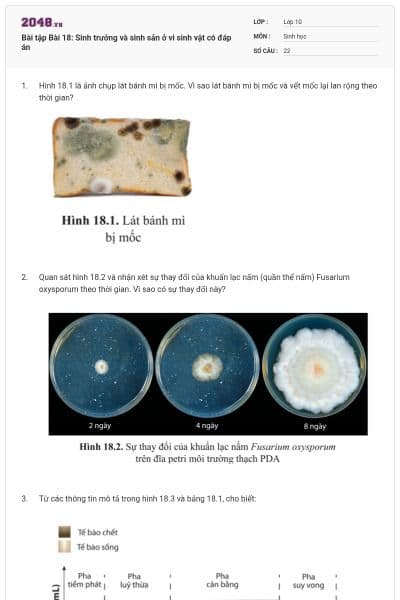
Bài tập Bài 18: Sinh trưởng và sinh sản ở vi sinh vật có đáp án

Chủ đề 9. Vi sinh vật
Đề thiSinh học - Lớp 10
15 câu Trắc nghiệm Sinh học 10 Cánh diều Bài 20 có đáp án
15 câu hỏi66 lượt thi
Đề thiSinh học - Lớp 10
15 câu Trắc nghiệm Sinh học 10 Cánh diều Bài 19 có đáp án
15 câu hỏi63 lượt thi
Đề thiSinh học - Lớp 10
15 câu Trắc nghiệm Sinh học 10 Cánh diều Bài 18 có đáp án
15 câu hỏi72 lượt thi
Đề thiSinh học - Lớp 10
15 câu Trắc nghiệm Sinh học 10 Cánh diều Bài 17 có đáp án
15 câu hỏi59 lượt thi
Đề thiSinh học - Lớp 10
Bài tập Bài 20: Thành tựu của công nghệ vi sinh vật và ứng dụng của vi sinh vật có đáp án
18 câu hỏi55 lượt thi
Đề thiSinh học - Lớp 10
Bài tập Bài 19: Quá trình tổng hợp, phân giải ở vi sinh vật và ứng dụng có đáp án
28 câu hỏi67 lượt thi